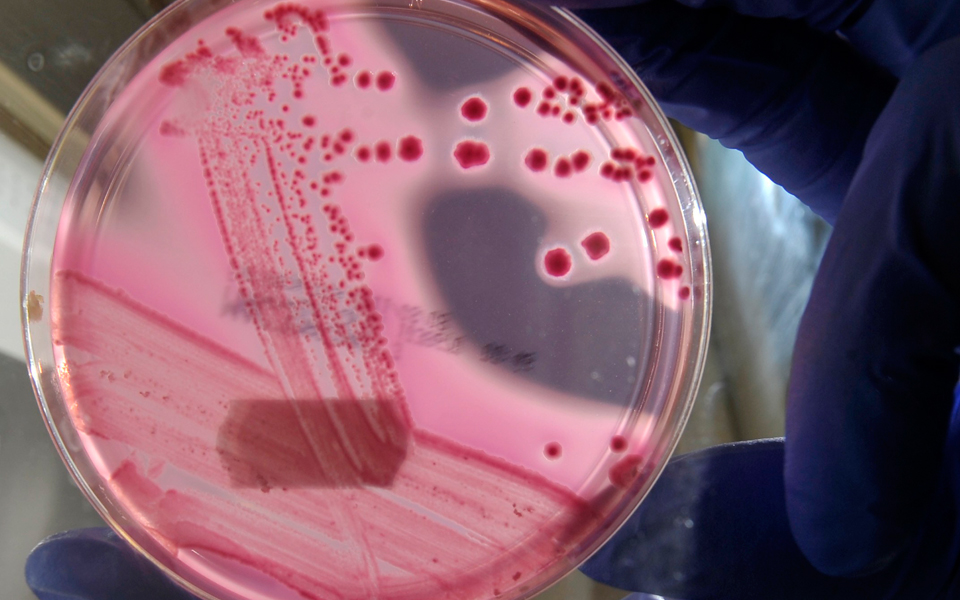
ο-έρπης-συνδράμει-στην-αντιμετώπιση-τ-2085522

Πάσχοντες από επιθετικό καρκίνο του δέρματος έτυχαν επιτυχούς θεραπείας με τη βοήθεια ενός σκευάσματος που βασίζεται στον ιό του έρπητα. Η καινοτόμος θεραπεία, σύμφωνα με ειδικούς, θα μπορούσε να ανοίξει τον δρόμο σε μια νέα γενιά αντικαρκινικών φαρμακευτικών σκευασμάτων.
Τα πρόσφατα αποτελέσματα σηματοδοτούν την πρώτη θετική έκβαση της τρίτης φάσης για την αντικαρκινική «ιο-θεραπεία», κατά την οποία η μια ασθένεια χρησιμοποιείται για να επιφέρει τη θεραπεία μιας άλλης.
Eφόσον λάβει άδεια κυκλοφορίας, το σκεύασμα T-Vec θα βρεθεί στα ράφια των φαρμακείων ώς την ερχόμενη χρονιά.
Η θεραπεία έχει τη δυνατότητα να θεραπεύσει τον καρκίνο ακόμα και όταν η νόσος έχει κάνει μεταστάσεις στα όργανα ολόκληρου του ανθρώπινου οργανισμού, προσφέροντας ελπίδα στους ασθενείς που θα βρεθούν αντιμέτωποι με τον θάνατο.
Ο Κέβιν Χάρινγκτον, καθηγητής Βιολογικών Αντικαρκινικών Θεραπειών στο Ινστιτούτο Αντικαρκινικής Ερευνας του Λονδίνου, ο οποίος και συντόνισε την τελευταία έρευνα, επισημαίνει ότι «η προσέγγιση αυτή γεννά μεγάλες ελπίδες, καθώς πρόκειται για την πρώτη φορά που η συγκεκριμένη “ιο- θεραπεία” καταγράφει καλά αποτελέσματα στην τρίτη φάση της κλινικής μελέτης».
Στην κλινική μελέτη συμμετείχαν 400 ασθενείς που έπασχαν από μελάνωμα. Ο ένας στους τέσσερις ανταποκρίθηκε στη θεραπεία και το 16% παρέμεινε σε ύφεση έξι μήνες από την ολοκλήρωση της θεραπείας. Το 10%, περίπου, των ασθενών είχε πλήρη ύφεση της νόσου και δεν κατέστη εφικτό να εντοπισθεί καρκίνος, γεγονός που ωθεί τους ιατρούς να πιστεύουν ότι αυτοί οι άρρωστοι θεραπεύτηκαν, κάτι το οποίο θα επανεξετάσουν ύστερα από πέντε χρόνια.
«Τα αποτελέσματα είναι εξαιρετικά ενθαρρυντικά», εξηγεί ο Χάρινγκτον, «ιδιαίτερα επειδή οι ασθενείς δεν μπορούσαν να υποβληθούν σε χειρουργική επέμβαση ή έπασχαν από μεταστατικό μελάνωμα, το οποίο δεν αντιδρούσε σε καμία από τις συμβατικές θεραπείες».
Η θεραπεία λειτουργεί εξαπολύοντας διπλή επίθεση εναντίον του καρκίνου. Βασίζεται σε μια γενετικώς εξουδετερωμένη εκδοχή του ιού του έρπητα που έχει τροποποιηθεί κατά τρόπο ώστε να σταματά την παραγωγή μιας πρωτεΐνης που επιτρέπει την προσβολή των υγιών κυττάρων. Τα καρκινικά κύτταρα παράγουν τη δική του εκδοχή της πρωτεΐνης, συμπληρώνοντας το έλλειμμα και επιτρέποντας στον τροποποιημένο ιό να αναπαραχθεί στον καρκινικό ιστό. Ο έρπης πολλαπλασιάζεται μέσα στα καρκινικά κύτταρα μέχρι αυτά να ανοίξουν και να απελευθερώσουν τον ιό στη γειτονική περιοχή, προκαλώντας μια αντίδραση του ανοσοποιητικού εναντίον του όγκου.
Μόλις τεθεί σε λειτουργία το ανοσοποιητικό εξαιτίας της θεραπείας T-Vec, φαίνεται ότι ενισχύεται η ικανότητά του για εντοπισμό και επίθεση εναντίον του καρκίνου σε όλο το σώμα. Οι επιστήμονες δεν γνωρίζουν για ποιο λόγο συμβαίνει αυτό.
Η θεραπεία χορηγείται με ένεση και κατά τη διάρκεια της έρευνας χορηγούνταν στους ασθενείς μία δόση ανά δύο εβδομάδες.